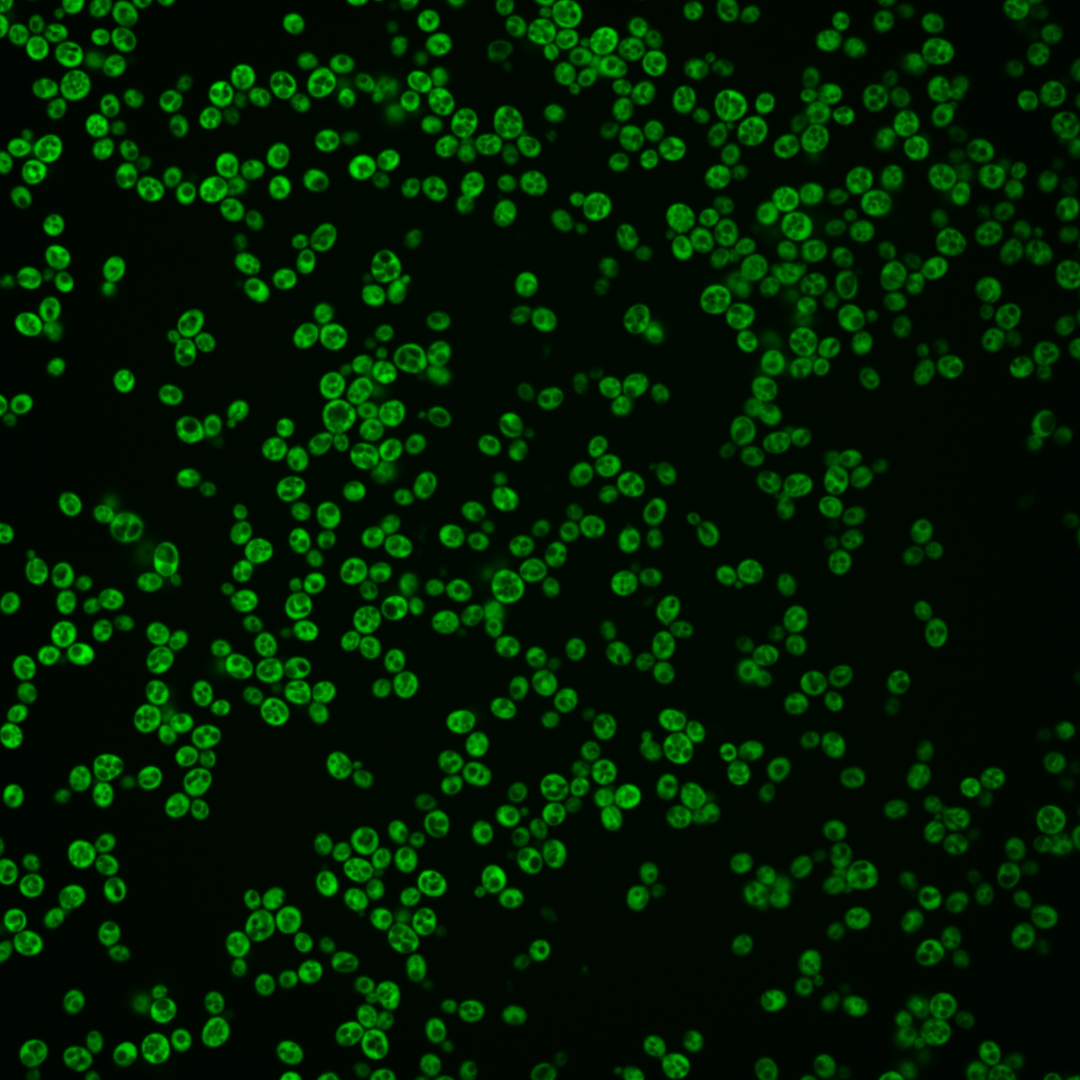
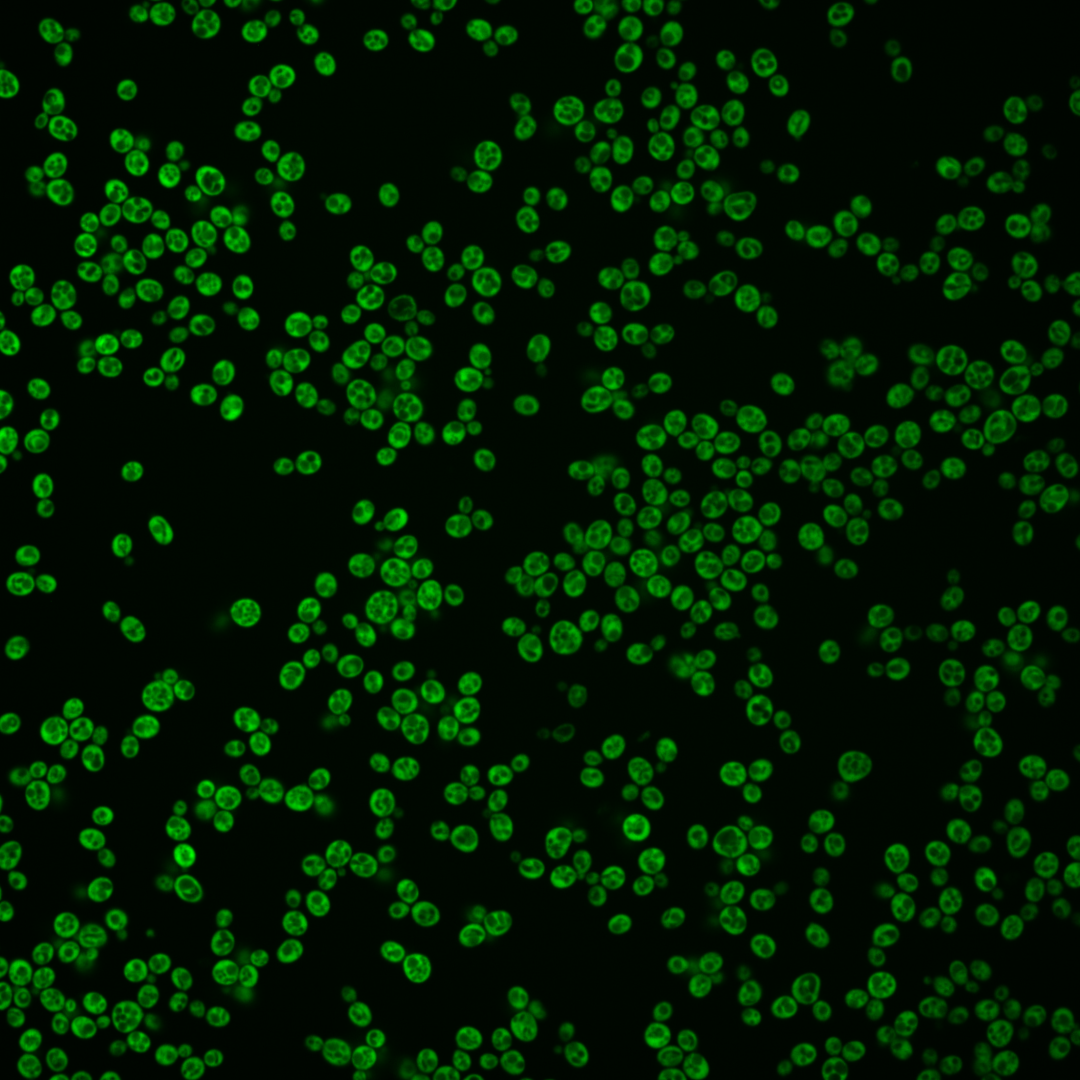
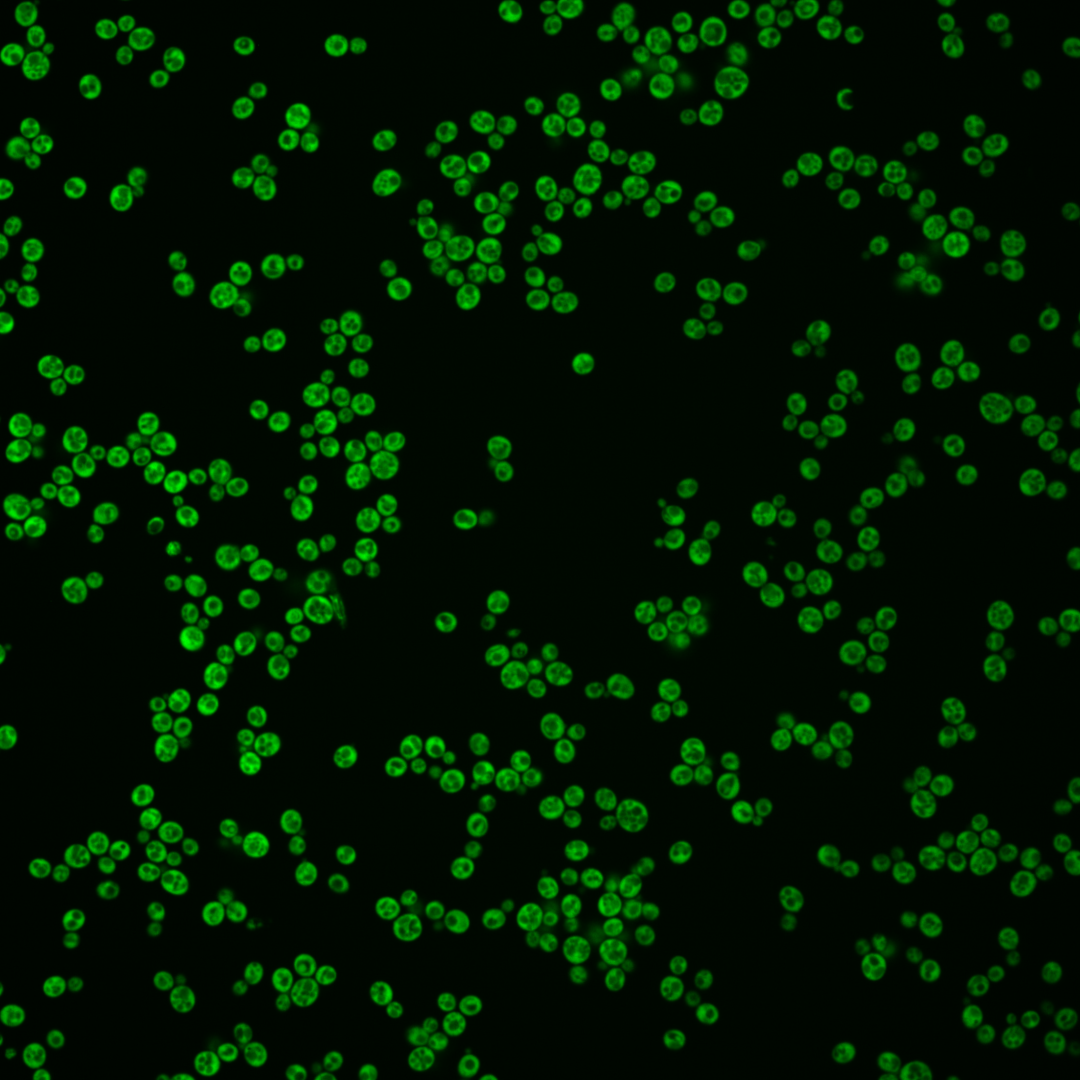
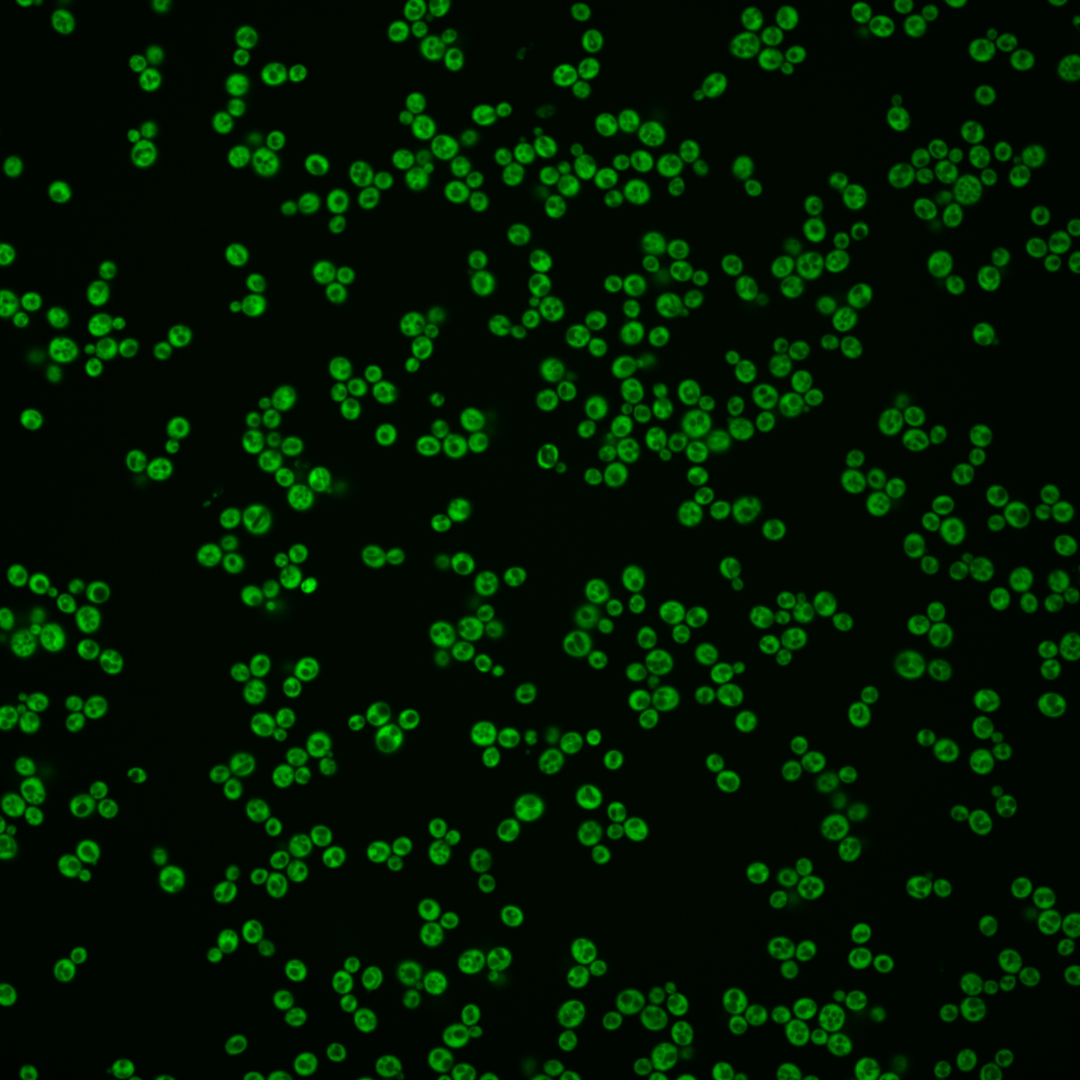
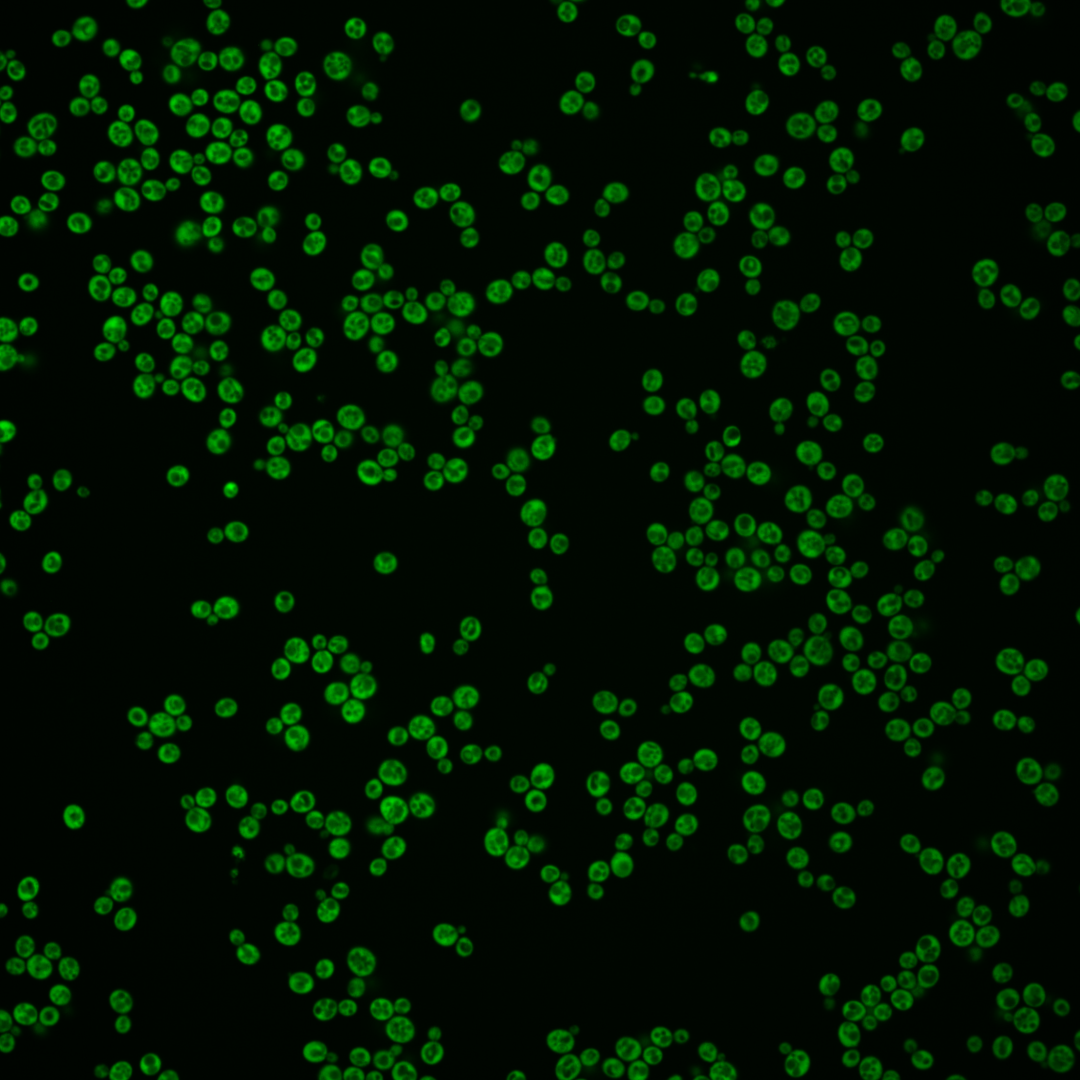

| Standard name | |
|---|---|
| Human Ortholog | |
| Description | Ribosomal 60S subunit protein L17B; required for processing of 27SB pre-rRNA and formation of stable 66S assembly intermediates; homologous to mammalian ribosomal protein L17 and bacterial L22; RPL17B has a paralog, RPL17A, that arose from the whole genome duplication |
Micrographs




















































































Sub-cellular Localization
Yeast GFP Assignment
Protein Abundance
Localization Change
External localization resources
| ensLOC | DeepLoc | |||||||||||||||||||||||
|---|---|---|---|---|---|---|---|---|---|---|---|---|---|---|---|---|---|---|---|---|---|---|---|---|
| Localization | WT1 | WT2 | WT3 | RAP60 | RAP140 | RAP220 | RAP300 | RAP380 | RAP460 | RAP540 | RAP620 | RAP700 | HU80 | HU120 | HU160 | rpd3Δ_1 | rpd3Δ_2 | rpd3Δ_3 | WT1 | WT2 | WT3 | AF100 | AF140 | AF180 |
| Cortical Patches | 0 | 1 | 0 | 0 | 2 | 4 | 7 | 13 | 16 | 38 | 33 | 38 | 0 | 0 | 0 | 0 | 0 | 0 | 0 | 0 | 1 | 0 | 0 | 0 |
| Bud | 1 | 0 | 0 | 0 | 1 | 1 | 0 | 0 | 0 | 2 | 1 | 0 | 0 | 0 | 0 | 0 | 0 | 0 | 0 | 2 | 8 | 0 | 2 | 2 |
| Bud Neck | 0 | 0 | 0 | 0 | 0 | 0 | 0 | 0 | 0 | 0 | 0 | 0 | 0 | 0 | 0 | 0 | 0 | 0 | 0 | 0 | 3 | 0 | 0 | 0 |
| Bud Site | 0 | 0 | 0 | 0 | 0 | 0 | 0 | 0 | 0 | 0 | 0 | 0 | 0 | 0 | 0 | 0 | 0 | 0 | – | – | – | – | – | – |
| Cell Periphery | 5 | 6 | 9 | 8 | 5 | 17 | 12 | 17 | 15 | 34 | 25 | 40 | 1 | 5 | 3 | 0 | 0 | 1 | 0 | 0 | 2 | 0 | 0 | 1 |
| Cytoplasm | 203 | 622 | 558 | 294 | 371 | 275 | 315 | 273 | 185 | 283 | 238 | 284 | 278 | 376 | 334 | 161 | 111 | 135 | 189 | 597 | 529 | 192 | 252 | 238 |
| Endoplasmic Reticulum | 2 | 8 | 14 | 10 | 16 | 41 | 65 | 59 | 47 | 102 | 62 | 103 | 8 | 14 | 1 | 3 | 6 | 4 | 1 | 5 | 11 | 1 | 12 | 11 |
| Endosome | 0 | 0 | 0 | 0 | 0 | 0 | 0 | 0 | 0 | 1 | 1 | 0 | 0 | 0 | 0 | 0 | 0 | 0 | 0 | 0 | 0 | 0 | 0 | 1 |
| Golgi | 0 | 0 | 2 | 0 | 1 | 1 | 10 | 20 | 18 | 36 | 33 | 49 | 0 | 0 | 0 | 0 | 0 | 1 | 0 | 0 | 0 | 0 | 0 | 1 |
| Mitochondria | 0 | 0 | 0 | 0 | 1 | 1 | 4 | 0 | 31 | 25 | 28 | 37 | 0 | 0 | 0 | 4 | 1 | 1 | 0 | 1 | 3 | 0 | 1 | 0 |
| Nucleus | 0 | 0 | 1 | 0 | 3 | 0 | 0 | 0 | 0 | 1 | 0 | 0 | 0 | 0 | 2 | 0 | 0 | 0 | 0 | 2 | 0 | 3 | 1 | 2 |
| Nuclear Periphery | 0 | 0 | 1 | 0 | 0 | 0 | 0 | 0 | 0 | 1 | 0 | 0 | 0 | 0 | 0 | 0 | 0 | 0 | 0 | 0 | 1 | 1 | 2 | 2 |
| Nucleolus | 0 | 0 | 0 | 0 | 1 | 0 | 0 | 0 | 0 | 3 | 1 | 0 | 0 | 0 | 3 | 1 | 0 | 0 | 0 | 0 | 0 | 3 | 5 | 8 |
| Peroxisomes | 0 | 0 | 0 | 0 | 0 | 0 | 0 | 0 | 0 | 0 | 0 | 0 | 0 | 0 | 0 | 0 | 0 | 0 | 0 | 0 | 0 | 0 | 0 | 0 |
| SpindlePole | 0 | 0 | 0 | 0 | 0 | 0 | 0 | 0 | 0 | 0 | 1 | 0 | 0 | 0 | 2 | 0 | 0 | 0 | 0 | 0 | 0 | 1 | 1 | 4 |
| Vac/Vac Membrane | 0 | 1 | 5 | 0 | 12 | 3 | 12 | 21 | 9 | 8 | 7 | 15 | 1 | 2 | 1 | 0 | 2 | 2 | 0 | 8 | 1 | 1 | 4 | 6 |
| Unique Cell Count | 205 | 629 | 573 | 304 | 397 | 328 | 397 | 377 | 282 | 457 | 367 | 475 | 285 | 384 | 340 | 163 | 113 | 138 | 192 | 622 | 573 | 211 | 286 | 286 |
| Labelled Cell Count | 211 | 638 | 590 | 312 | 413 | 343 | 425 | 403 | 321 | 534 | 430 | 566 | 288 | 397 | 346 | 169 | 120 | 144 | 192 | 622 | 573 | 211 | 286 | 286 |
Yeast GFP Assignment
Protein Abundance
| Screen | WT1 | WT2 | WT3 | RAP60 | RAP140 | RAP220 | RAP300 | RAP380 | RAP460 | RAP540 | RAP620 | RAP700 | HU80 | HU120 | HU160 | rpd3Δ_1 | rpd3Δ_2 | rpd3Δ_3 | AF100 | AF140 | AF180 |
|---|---|---|---|---|---|---|---|---|---|---|---|---|---|---|---|---|---|---|---|---|---|
| Mean Cell GFP Intensity (1e-4) | 78.4 | 59.7 | 59.9 | 53.3 | 31.9 | 32.3 | 26.9 | 24.8 | 22.2 | 22.8 | 22.3 | 20.9 | 56.9 | 53.5 | 49.9 | 75.6 | 95.8 | 82.6 | 61.8 | 64.6 | 63.5 |
| Std Deviation (1e-4) | 13.3 | 12.7 | 14.9 | 10.7 | 9.5 | 6.7 | 5.8 | 5.6 | 6.4 | 5.6 | 5.4 | 4.4 | 14.3 | 10.7 | 11.4 | 27.8 | 27.8 | 28.8 | 20.0 | 20.4 | 23.0 |
| Intensity Change (Log2) | – | – | – | -0.17 | -0.91 | -0.89 | -1.16 | -1.27 | -1.44 | -1.4 | -1.43 | -1.52 | -0.07 | -0.16 | -0.27 | 0.33 | 0.68 | 0.46 | 0.04 | 0.11 | 0.08 |
Localization Change
| Localization | RAP60 | RAP140 | RAP220 | RAP300 | RAP380 | RAP460 | RAP540 | RAP620 | RAP700 | HU80 | HU120 | HU160 | rpd3Δ_1 | rpd3Δ_2 | rpd3Δ_3 |
|---|---|---|---|---|---|---|---|---|---|---|---|---|---|---|---|
| Cortical Patches | 0 | 0 | 0 | 0 | 4.5 | 5.8 | 7.0 | 7.3 | 6.9 | 0 | 0 | 0 | 0 | 0 | 0 |
| Bud | 0 | 0 | 0 | 0 | 0 | 0 | 0 | 0 | 0 | 0 | 0 | 0 | 0 | 0 | 0 |
| Bud Neck | 0 | 0 | 0 | 0 | 0 | 0 | 0 | 0 | 0 | 0 | 0 | 0 | 0 | 0 | 0 |
| Bud Site | 0 | 0 | 0 | 0 | 0 | 0 | 0 | 0 | 0 | 0 | 0 | 0 | 0 | 0 | 0 |
| Cell Periphery | 1.1 | -0.4 | 3.1 | 1.5 | 2.7 | 3.1 | 4.7 | 4.2 | 5.2 | 0 | -0.3 | 0 | 0 | 0 | 0 |
| Cytoplasm | -0.6 | -3.0 | -7.4 | -9.2 | -11.4 | -12.9 | -14.6 | -13.5 | -15.2 | 0.1 | 0.5 | 0.8 | 1.0 | 0.5 | 0.3 |
| Endoplasmic Reticulum | 0.7 | 1.4 | 6.1 | 7.8 | 7.5 | 7.6 | 10.0 | 7.9 | 9.8 | 0.3 | 1.1 | -2.5 | 0 | 0 | 0 |
| Endosome | 0 | 0 | 0 | 0 | 0 | 0 | 0 | 0 | 0 | 0 | 0 | 0 | 0 | 0 | 0 |
| Golgi | 0 | 0 | 0 | 0 | 5.0 | 5.5 | 6.4 | 6.8 | 7.5 | 0 | 0 | 0 | 0 | 0 | 0 |
| Mitochondria | 0 | 0 | 0 | 0 | 0 | 8.1 | 5.7 | 6.7 | 6.8 | 0 | 0 | 0 | 0 | 0 | 0 |
| Nucleus | 0 | 0 | 0 | 0 | 0 | 0 | 0 | 0 | 0 | 0 | 0 | 0 | 0 | 0 | 0 |
| Nuclear Periphery | 0 | 0 | 0 | 0 | 0 | 0 | 0 | 0 | 0 | 0 | 0 | 0 | 0 | 0 | 0 |
| Nucleolus | 0 | 0 | 0 | 0 | 0 | 0 | 0 | 0 | 0 | 0 | 0 | 0 | 0 | 0 | 0 |
| Peroxisomes | 0 | 0 | 0 | 0 | 0 | 0 | 0 | 0 | 0 | 0 | 0 | 0 | 0 | 0 | 0 |
| SpindlePole | 0 | 0 | 0 | 0 | 0 | 0 | 0 | 0 | 0 | 0 | 0 | 0 | 0 | 0 | 0 |
| Vacuole | 0 | 2.5 | 0 | 2.5 | 4.3 | 0 | 1.3 | 0 | 2.7 | 0 | 0 | 0 | 0 | 0 | 0 |
External localization resources
Images






























Protein Concentration and Protein Localization Data
| R1 | R2 | R3 | ||||||||||||||||
|---|---|---|---|---|---|---|---|---|---|---|---|---|---|---|---|---|---|---|
| G1 Pre-START | G1 Post-START | S/G2 | Metaphase | Anaphase | Telophase | G1 Pre-START | G1 Post-START | S/G2 | Metaphase | Anaphase | Telophase | G1 Pre-START | G1 Post-START | S/G2 | Metaphase | Anaphase | Telophase | |
| Concentration | 64.0318 | 75.6805 | 71.222 | 74.099 | 69.4882 | 66.282 | 55.5708 | 79.6261 | 74.0223 | 71.3023 | 70.4472 | 74.7324 | 57.5503 | 70.8526 | 63.426 | 66.0915 | 62.6857 | 66.3153 |
| Actin | 0.0064 | 0.0007 | 0.0018 | 0.0109 | 0.0009 | 0.0022 | 0.0215 | 0.0003 | 0.0055 | 0.0001 | 0.0053 | 0.002 | 0.0095 | 0.0002 | 0.0018 | 0.0002 | 0.0069 | 0.0358 |
| Bud | 0.0015 | 0.0008 | 0.0014 | 0.0012 | 0.0008 | 0.0021 | 0.0034 | 0.0004 | 0.0018 | 0.0011 | 0.0014 | 0.002 | 0.0009 | 0.0007 | 0.0008 | 0.0006 | 0.0004 | 0.0004 |
| Bud Neck | 0.0013 | 0.0008 | 0.0013 | 0.0011 | 0.0012 | 0.0042 | 0.0008 | 0.0003 | 0.0005 | 0.0004 | 0.0005 | 0.0008 | 0.0007 | 0.0003 | 0.0008 | 0.0007 | 0.0006 | 0.0019 |
| Bud Periphery | 0.0019 | 0.0004 | 0.0011 | 0.0007 | 0.001 | 0.0025 | 0.0066 | 0.0001 | 0.0012 | 0.0004 | 0.0024 | 0.002 | 0.0019 | 0.0021 | 0.0008 | 0.0002 | 0.0002 | 0.0001 |
| Bud Site | 0.0022 | 0.0016 | 0.001 | 0.0004 | 0.0009 | 0.0004 | 0.0016 | 0.0002 | 0.0009 | 0.0002 | 0.0002 | 0.0002 | 0.0005 | 0.0003 | 0.0017 | 0.0001 | 0.0002 | 0.0001 |
| Cell Periphery | 0.0124 | 0.0145 | 0.0049 | 0.0033 | 0.0059 | 0.0028 | 0.0039 | 0.0013 | 0.0036 | 0.0427 | 0.0009 | 0.0008 | 0.0063 | 0.0014 | 0.0086 | 0.0006 | 0.0008 | 0.0002 |
| Cytoplasm | 0.7011 | 0.8961 | 0.8435 | 0.7181 | 0.7391 | 0.7828 | 0.616 | 0.9737 | 0.8682 | 0.7179 | 0.8433 | 0.8386 | 0.7509 | 0.9662 | 0.854 | 0.8433 | 0.8411 | 0.8274 |
| Cytoplasmic Foci | 0.0021 | 0.002 | 0.0047 | 0.0018 | 0.0122 | 0.0048 | 0.0114 | 0.0018 | 0.0034 | 0.001 | 0.0102 | 0.0073 | 0.0073 | 0.0012 | 0.0061 | 0.0046 | 0.008 | 0.0063 |
| Eisosomes | 0.0002 | 0 | 0.0001 | 0 | 0.0001 | 0 | 0.0003 | 0 | 0.0003 | 0 | 0.0001 | 0 | 0.0003 | 0 | 0.0004 | 0 | 0.0001 | 0 |
| Endoplasmic Reticulum | 0.0565 | 0.0182 | 0.0274 | 0.0071 | 0.0131 | 0.0289 | 0.0553 | 0.0035 | 0.021 | 0.0032 | 0.0385 | 0.0553 | 0.0789 | 0.0037 | 0.0219 | 0.016 | 0.0051 | 0.0795 |
| Endosome | 0.0126 | 0.0021 | 0.0083 | 0.0101 | 0.0212 | 0.0343 | 0.0353 | 0.0026 | 0.012 | 0.0063 | 0.0464 | 0.0319 | 0.0235 | 0.0028 | 0.0152 | 0.0165 | 0.0322 | 0.0204 |
| Golgi | 0.0015 | 0.0004 | 0.0015 | 0.0097 | 0.0022 | 0.003 | 0.0053 | 0.0004 | 0.0139 | 0.0001 | 0.0136 | 0.0074 | 0.0036 | 0.0002 | 0.0017 | 0.0007 | 0.0034 | 0.0029 |
| Lipid Particles | 0.0011 | 0.0012 | 0.0014 | 0.0005 | 0.0059 | 0.0006 | 0.0042 | 0.0003 | 0.0011 | 0.0005 | 0.0002 | 0.0002 | 0.0028 | 0.0001 | 0.0017 | 0.0002 | 0.0069 | 0.0006 |
| Mitochondria | 0.0044 | 0.0004 | 0.0067 | 0.0027 | 0.0083 | 0.0133 | 0.0435 | 0.0002 | 0.0095 | 0.0002 | 0.0212 | 0.0067 | 0.0046 | 0.0004 | 0.0015 | 0.0003 | 0.0016 | 0.0029 |
| None | 0.0015 | 0.0006 | 0.0009 | 0.0001 | 0.0039 | 0.0007 | 0.0245 | 0.0001 | 0.0016 | 0.0001 | 0.0007 | 0.0004 | 0.0043 | 0.0002 | 0.0097 | 0.0002 | 0.0005 | 0.0005 |
| Nuclear Periphery | 0.0258 | 0.0049 | 0.0084 | 0.0082 | 0.0083 | 0.0108 | 0.041 | 0.0013 | 0.0054 | 0.008 | 0.0023 | 0.0131 | 0.0242 | 0.0011 | 0.0082 | 0.0055 | 0.0164 | 0.0037 |
| Nucleolus | 0.0013 | 0.0002 | 0.0007 | 0.0001 | 0.003 | 0.0009 | 0.0097 | 0 | 0.0007 | 0.0003 | 0 | 0 | 0.0005 | 0 | 0.001 | 0.0001 | 0.0002 | 0 |
| Nucleus | 0.0089 | 0.0019 | 0.0041 | 0.0032 | 0.0044 | 0.0054 | 0.0179 | 0.0007 | 0.0022 | 0.0026 | 0.0008 | 0.0021 | 0.0066 | 0.0012 | 0.0046 | 0.0019 | 0.0021 | 0.0009 |
| Peroxisomes | 0.0001 | 0.0001 | 0.0002 | 0.0001 | 0.0007 | 0.0002 | 0.0059 | 0 | 0.0002 | 0 | 0.0001 | 0.0001 | 0.0003 | 0 | 0.0004 | 0 | 0.0009 | 0.0007 |
| Punctate Nuclear | 0.0002 | 0.0001 | 0.0002 | 0 | 0.0015 | 0.0001 | 0.0027 | 0 | 0.0001 | 0 | 0.0001 | 0.0001 | 0.0026 | 0 | 0.0007 | 0 | 0.0029 | 0.0014 |
| Vacuole | 0.1371 | 0.0503 | 0.0685 | 0.1895 | 0.1386 | 0.0756 | 0.0579 | 0.0108 | 0.0355 | 0.1687 | 0.0068 | 0.0188 | 0.0531 | 0.0147 | 0.0477 | 0.0938 | 0.0548 | 0.009 |
| Vacuole Periphery | 0.0199 | 0.0027 | 0.0121 | 0.0311 | 0.0267 | 0.0244 | 0.0312 | 0.0017 | 0.0115 | 0.046 | 0.0049 | 0.01 | 0.0167 | 0.0031 | 0.0108 | 0.0146 | 0.0146 | 0.0053 |
Sequencing Data
| R1 | R2 | |||||||||
|---|---|---|---|---|---|---|---|---|---|---|
| G1 Post-START | S/G2 | Metaphase | Anaphase | Telophase | G1 Post-START | S/G2 | Metaphase | Anaphase | Telophase | |
| Gene Expression | 1306.1923 | 1388.0357 | 1479.693 | 1276.4698 | 1514.3867 | 1251.8198 | 1133.4452 | 1186.7644 | 1198.7613 | 1067.9743 |
| Translational Efficiency | 1.3784 | 1.4404 | 1.4057 | 1.6267 | 1.5915 | 1.5314 | 1.5456 | 1.7079 | 1.5989 | 1.7814 |
Hit Data
| Dataset | Hit |
|---|---|
| Protein Concentration | ✘ |
| Protein Localization | ✘ |
| Gene Expression | ✘ |
| Translational Efficiency | ✘ |
Endocytosis
| Temp | Actin Patch (Sac6-tdTomato) | Cortical Patch (Sla1-GFP) | Late Endosome (Snf7-GFP) | Vacuole (Vph1-GFP) |
|---|---|---|---|---|
| 37℃ | ||||
| RT |
Cell Cycle Omics
CYCLoPs (Rpl17b-GFP)
| Gene / Allele | Actin Patch (Sac6-tdTomato) | Cortical Patch (Sla1-GFP) | Late Endosome (Snf7-GFP) | Vacuole (Sac6-tdTomato) |
|---|
| Gene | Images |
|---|
| Gene | Images |
|---|
Images are not yet available
Images are not yet available